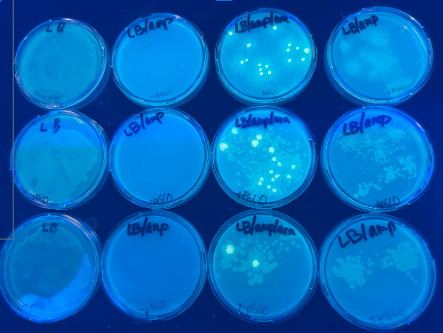
2

HES Weekly Scoop Parent Edition for the week of January 12:

Hermit Headlines for the week of January 12th: https://drive.google.com/file/d/1gjXORI3nO10srhjPTSyJL-ifD6LUlGkz/view?usp=drive_link

On Friday night, the Hermitage Jr. and Sr. Girls teams reigned victorious against the Bearden Bears. GO LADY HERMITS!

🎉 1,000 CAREER POINTS! 🎉
Congratulations to Ny’asha Tatum on reaching an incredible milestone — 1,000 career points as a Lady Hermit Basketball player!
This achievement is a reflection of Ny’asha’s hard work, dedication, and relentless drive on the court. She has been a consistent leader, competitor, and teammate who represents Hermitage High School with pride every time she steps into the game.
We are proud of your accomplishments and excited to see what’s still ahead. Way to leave your mark, Ny’asha!
🏀❤️ Hermit Pride ❤️🏀

Learning by doing! Our ninth-grade Physical Science students were fully engaged while playing Ion Caramba, an interactive activity designed to help them master ionic bonding through collaboration, problem-solving, and the real-time application of science concepts.
The Weekly Hermit. Week of January 12th-16th

HES 1st grade took Science class outside!

History came alive in Ms. Alexis Dunaway's 7th and 8th grade classes during the Haunted High School project! Students researched influential Americans from history and highlighted their impact on the nation. By choosing to present through posters, costumes, or monologue readings, students demonstrated creativity while strengthening research and presentation skills.






Ms. Alexis Dunaway's 8th-grade science students brought learning to life by designing and building magnetic roller coasters!
Through this hands-on project, students demonstrated their understanding of forces, motion, and magnetism while also strengthening creativity, critical thinking, and engineering skills.
We are so proud of our students for turning science concepts into innovative, working designs—this is what real-world learning looks like!



💙✨ Prom With Purpose Closet – Donations Needed! ✨💙
Hermitage High EAST is proud to host the Prom With Purpose Closet, an initiative designed to ensure every student has access to formal wear for prom and special events.
We are currently accepting new or gently used formal dresses, suits, and accessories. All donated items will be made available to students at no cost, allowing each student to select one free dress or suit.
đź“… Donation Window: Now through February 6
📍 Drop-Off Location: Hermitage High School Front Office
⏰ Drop-Off Times: 8:00 a.m. – 3:00 p.m.
For out-of-town donations or special arrangements, please contact Mrs. Erin Hilliard.
Thank you for supporting our students and helping make prom memorable for everyone!
Hermitage High EAST is proud to host the Prom With Purpose Closet, an initiative designed to ensure every student has access to formal wear for prom and special events.
We are currently accepting new or gently used formal dresses, suits, and accessories. All donated items will be made available to students at no cost, allowing each student to select one free dress or suit.
đź“… Donation Window: Now through February 6
📍 Drop-Off Location: Hermitage High School Front Office
⏰ Drop-Off Times: 8:00 a.m. – 3:00 p.m.
For out-of-town donations or special arrangements, please contact Mrs. Erin Hilliard.
Thank you for supporting our students and helping make prom memorable for everyone!

Today, Hermitage High School kicked off 2026 by welcoming our students back after winter break! It was great to see smiling faces in the halls, classrooms full of learning, and students ready to start strong for the second semester.
We’re excited for all the growth, opportunities, and successes ahead. Let’s make it a great year—together!
🖤❤️ Hermits L.E.A.D. the Way ❤️🖤
We’re excited for all the growth, opportunities, and successes ahead. Let’s make it a great year—together!
🖤❤️ Hermits L.E.A.D. the Way ❤️🖤
HES Weekly Scoop Parent Edition for the week of January 5:
Menu:
Tuesday: Pizza Stick, Tator Tots, Fruit
Wednesday: Orange Chicken, Veggies, Fruit
Thursday: Hamburger Steak, Mashed Potatoes, Beans, Fruit
Friday: Country Breakfast Platter, Veggies, Fruit

The Weekly Hermit. Week of January 5th-9th.

Junie B. Jones in Little Rock served lots of laughs and fun for our HES 2nd grade students.

3rd grade students want to say "Thank you" to the community for helping make their Christmas celebration at school one to remember.

Proud of our Hermitage Boys Basketball team for an outstanding performance at the Westside Christian Tournament! The Hermits battled hard and came up just short in a close championship game against Claiborne Academy, finishing 47–49.
Great effort, teamwork, and determination all tournament long. Keep working, Hermits — big things ahead! ❤️🖤

Proud of our the HHS Senior Girls Basketball players and coaches on their win!

We welcomed a special visitor yesterday to HES. The kids absolutely loved his visit. Thank you to the SR Girls Basketball Team for making this happen.

HHS students attended a lab day at ASMSA in Hot Springs, where they completed pGLO Bacterial Transformation and Gel Electrophoresis labs. This hands-on experience gave students exposure to advanced lab techniques and real-world science. We’re proud of our Hermits! 🖤❤️

HHS Beta Club students worked on packing shoeboxes and writing personalized notes for their Operation Christmas Child service project.





